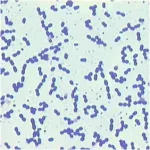
Enterococcus in gram-stain - Enterococcus faecalisin gram stain

The most common gram-positive cocci of medical importance belong to Staphylococcus, Streptococcus, and Enterococcus genera*. etc.*Most organisms belonging to these genera are non-motile and do not form spores (exception; Sporosarcina ureae is spore-forming gram-positive cocci). Other gram-positive cocci areMicrococcus, Peptococcus, and Peptostreptococcus. Organisms belonging to these genera are part of the normal flora of the skin and are rare human pathogens.
Two main criteria distinguish staphylococci and streptococci
- Staphylococci appear in grapelike clusters, whereas streptococci are in chains
- Staphylococci produce catalase enzyme, whereas streptococci do not.

Staphylococcusspecies
Staphylococcus genus**contains more than 30 species, two of which, Staphylococcus aureus and S. saprophyticus are commonly pathogenic in humans. S. epidermidis, primarily a normal skin flora of skin can also cause bloodstream infections in neonates and people with prosthetic implants and catheters.

Staphylococcus aureus
Staphylooccus aureus is a normal flora of the nose and skin but also one of the notorious pathogens. It is catalase and coagulase positive gram-positive cocci. Major diseases caused by S. aureus are sepsis, pneumonia, wound infections, folliculitis, necrotizing fasciitis, scalded skin syndrome, surgical site infection, toxic shock syndrome, and food poisoning.
This post discusses theproperties ofS. aureus, disease, and lab diagnosis.
Major virulence factors of S. aureus are coagulase, collagenase, hyaluronidase, immunoglobulin proteases, protein A, toxic shock syndrome toxin (TSST-1), enterotoxin, exfoliatin, etc.Â
Find more about theStaphylococcus aureusvirulence factors.
Some strains of S. aureus, such as methicillin-resistantStaphylococcus aureus(MRSA), are highly resistant to multiple antibiotics. Bactericidal agent vancomycin is an effective treatment of MRSA infections.
Staphylococcus saprophyticus
Staphylococcus saprophyticus is found primarily on the mucosa of the genital tract in young women and causes urinary tract infections (UTI), especially cystitis in sexually active young women. In this group, it is second to E. coli as a cause of community-acquired UTIs.
Read more about Staphylococcus saprophyticuscharacteristics and diagnosis.
Staphylococcus epidermidis
Staphylococcus epidermidisare normal flora of the human skin and mucous membranes. They are opportunistic pathogens and can cause neonatal sepsis, prosthetic hip infection, intravascular catheter infection, and endocarditis on prosthetic heart values.
These coagulase-negative staphylococci (CONS) do not produce exotoxins, but some strains may produce glycocalyx, which helps them to adhere to foreign bodies such as prosthetic implants and catheters.
Streptococcus species
Streptococci are spherical gram-positive cocci arranged in pairs or chains. All streptococci are catalase-negative. Traditionally, streptococci are identified based on hemolysis type shown in blood agar cell wall structure and reaction of antibodies to the specific bacterial antigen. S. pneumoniae and viridans streptococci are alpha-hemolytic, S. agalactiaeand S. pyogenesare beta-hemolytic.
C-carbohydrate antigen and M protein are two important antigens of beta-hemolytic streptococci. Based on antigenic differences in C carbohydrate, beta-hemolytic streptococci are arranged into groups A-U, also known as Lancefield grouping. Some other streptococci are non-hemolytic (gamma-hemolysis). Currently, the molecular analysis of the 16S ribosomal ribonucleic acid (rRNA) sequences is helpful to identify the isolates. Streptococci cause various infections, such as pneumonia, sore throat, pyogenic skin infections, and meningitis.
Streptococcus pyogenes
Group A Streptococcus (S.pyogenes), also known as “flesh-eating bacteria,” is the leading bacterial cause of pharyngitis (strep. throat) and cellulitis. It also causes impetigo, necrotizing fasciitis, scarlet fever, and streptococcal toxic shock syndrome. Rheumatic fever and acute post-streptococcal glomerulonephritis (PSGN) are the post-streptococcal sequelae of S. pyogenes infections. It is beta-hemolytic, bacitracin-sensitive, and pyrrolidonyl arylamidase (PYR) test positive.
Read more aboutcharacteristics, disease and tests for the identification ofStreptococcus pyogenes.
M proteins, hyaluronic acid capsule, adhesions, hemolysins, pyrogenic exotoxins, and spreading factors (deoxyribonucleases, streptokinase, and hyaluronidase) are the major virulence factors of S. pyogenes.
Read more aboutvirulence factors ofS. pyogenes.
Streptococcus pneumoniae
Streptococcus pneumoniae(pneumococcus) is the normal upper respiratory tract flora and the most common cause of community-acquired pneumonia. It also causes bacteremia, meningitis, otitis media, sinusitis, and conjunctivitis. Pneumococci are gram-positive lancet-shaped diplococci. They produce alpha-hemolysis on blood agar, optochin-sensitive, and bile soluble.

Find more aboutproperties, pathogenesis and diagnosis ofS. pneumoniae
Autolysins, IgA1 proteases, pneumolysin, polysaccharide capsules, and teichoic acids are the major virulence factors ofS. pneumoniae*.*There are >90 different capsular serotypes of S. pneumoniae. The capsular serotype of an individual pneumococcal isolate is determined by using quellung reaction.
Streptococcus agalactiae
Group B Streptococcus (S. agalactiae) colonizes the genital tract of some women. It is the leading cause of neonatal sepsis, pneumonia, and meningitis. The infection is acquired before or during the birthing process. Because of this CDC recommends screening of all pregnant women for GBS carriage between 35 to 35 weeks of gestation.
S. agalactiae is beta-hemolytic streptococci that are resistant to bacitracin and hydrolyze hippurate. CAMP test positive results are the special diagnostic tests for identifying S. agalactiae.
Find more aboutStreptococcus agalactiaeproperties, pathogenesis and lab diagnosis.
Viridans Streptococci
Viridians group streptococci are also α-hemolytic streptococci, but unlike *S. pneumoniae,*they are optochin resistant and bile-insoluble. Viridans streptococci are normal flora of the human oral cavity and pharynx but are one of the major causes of bacterial endocarditis.
Streptococcus mutans, Streptococcus mitis, and Streptococcus sanguinis are the medically important species of viridans group of streptococci. S. mutanssynthesizes polysaccharide dextran and is responsible for forming dental plaque leading to dental caries.
Find more aboutviridans streptococci, their pathogenesis and lab diagnosis.
Group D streptococci
These include enterococci (e.g., Enterococcus faecalisand Enterococcus faecium) and nonenterococci (e.g., S. bovis). Group D streptococci are mostly α-hemolytic, but some are β-hemolytic, and others are nonhemolytic.
Enterococci are members of the normal flora of the colon and are noted for their ability to cause urinary, biliary, and cardiovascular infections. Enterococcus faecalis is an important cause of hospital-acquired UTIs and endocarditis. Strains of E. faeciumand E. faecalis are vancomycin-resistant (also known as vancomycin-resistant enterococci-VRE).
Find more aboutproperties, pathogenesis, and lab diagnosis ofEnterococcus faecalis
Micrococcus
Micrococci are gram-positive cocci usually arranged in tetrads or pairs and are part of the normal flora of the skin. Micrococci are usually considered contaminants of clinical specimens (blood) and are rarely implicated as a cause of human infections.
The two most common species of micrococci are Micrococcus luteusand Micrococcus roseus. Micrococcusgives non-hemolytic colonies with a wide variety of pigments (white, tan, yellow, orange, or pink) in blood agar. They can be differentiated from staphylococci using microdase test,**micrococci are modified oxidase (microdase) positive and susceptible to bacitracin.
Find more on thedifferentiation of staphylococci from micrococci.
Peptococcus
Peptococci are anaerobic gram-positive cocci, resembling staphylococci, found as members of the normal flora of the mouth and colon. They are also isolated from abscesses of various organs, usually from mixed anaerobic infections. Peptococcus nigeris the only species of this genus.
Peptostreptococcus
Peptostreptococci are anaerobic gram-positive cocci found as members of the normal flora of the mouth, gut, colon, and genital tract of women. Peptostreptococci are also isolated from abscesses of various organs, usually from mixed anaerobic infections. Â
These organisms grow well under anaerobic or microaerophilic conditions and produce variable hemolysis. Peptostreptococcus magnus and Peptostreptococcus anaerobiusare clinically important species.
References
- Madigan, M., Martinko, J., Stahl, D., & Clark, D. (2012). Brock Biology of Microorganisms (13th ed). Pearson Education
- Bailey & Scott’s Diagnostic Microbiology, Forbes, 11th edition
- Review of Medical Microbiology and Immunology, Lange Medical Books, 13th edition